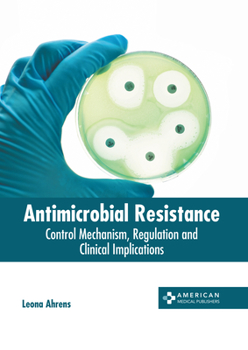
Hardcover Antimicrobial Resistance: Control Mechanism, Regulation and Clinical Implications Book

Antimicrobial Resistance: Control Mechanism, Regulation and Clinical Implications
Antimicrobial resistance (AMR) refers to the decreased effectiveness of a medication, such as an antineoplastic or antimicrobial, to treat a disease or condition. Resistance among microbes is common due to random mutations. Drug resistance occurs when parasites, fungi, viruses and bacteria transform over time and they do not respond to the medications. The clinical implication of AMR is that it makes the treatment of infections difficult while simultaneously increasing the risk of spreading the diseases. This resistance may develop naturally through sustained exposure to antimicrobials. There are some specific antiviral drugs that are utilized for treating various viral infections, such as hepatitis B, influenza, HIV and herpes. These drugs stop the viruses from reproducing by blocking the key stages of replication cycle in infected cells. Some strains of each virus have developed resistance to the administered drugs. AMR can be prevented and controlled by the consumption of antibiotics only when they are required, modifying and inactivating a drug, and active efflux of a drug. This book elucidates the clinical aspects and innovative models around prospective developments in the study of antimicrobial resistance. It aims to serve as a resource guide for students and experts alike and contribute to the growth of research on the control mechanism, regulation and clinical implications of antimicrobial resistance.
Format:Hardcover
Language:English
ISBN:1639278850
ISBN13:9781639278855
Release Date:September 2023
Publisher:American Medical Publishers
Length:250 Pages
Weight:1.93 lbs.
Dimensions:0.6" x 8.5" x 11.0"
Customer Reviews
0 rating